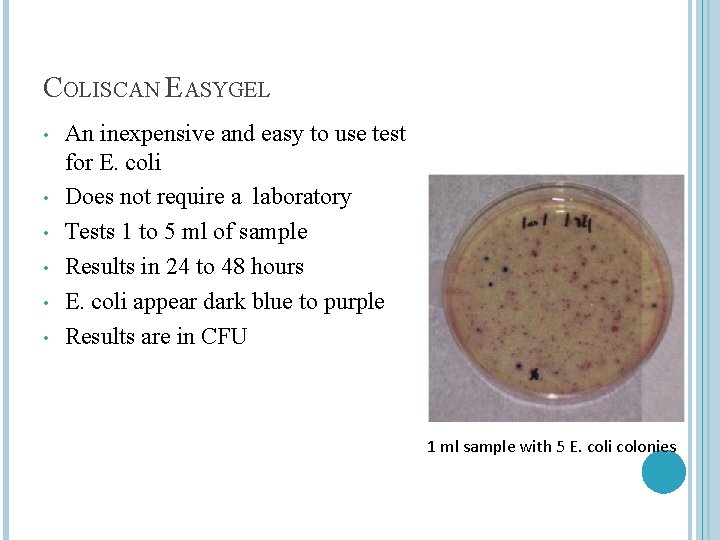
COLISCAN EASYGEL • • • An inexpensive and easy to use test for E.

HOW TO MONITOR FOR BACTERIA AND SEWAGE James

HOW TO MONITOR FOR BACTERIA AND SEWAGE James Beckley Virginia DEQ VCWQ Summit October 27, 2012

WHY MONITOR FECAL BACTERIA AND SEWAGE Fecal bacteria is the largest impairment source of streams in Virginia; currently at 9, 154 miles Waterbodies with fecal bacteria often have other issues such as increased sediment and nutrients High levels of fecal bacteria and sewage in waterbodies increase the risk of illness Sewage (leaking sewer lines, septic systems, straight pipes), the largest or second source of fecal bacteria in nearly any given waterbody

BEFORE WE GO FURTHER… Culture tests have results reported in CFU or MPN CFU or Colony Forming Units is the number of bacteria colonies that formed from the original bacteria in the sample MPN or Most Probable Number is a statistical estimate of the number of bacteria that was present in the sample Except for shellfish standards, Virginia Water Quality Standards only reference values by CFU � MPN data can still be used to gauge water quality

ESCHERICHIA COLI (E. COLI) Gram negative, rod shaped, facultative anaerobic bacteria Normally found in the digestive tracks of warm blooded animals Currently monitored in fresh waterbodies � Samples with >235 E. coil or an average >126 per 100 ml sample indicates excessive bacteria levels

FECAL COLIFORM Family of coliform bacteria species only found in the digestive tract of warm blooded animals � E. coli and other species are members � Since 2002, no longer used for freshwater recreation (e. g. swimming) � Still used by VDH to determine closure of shellfish beds. Average fecal coliform levels must be less than 14 and single maximum readings no more than 49 MPN or 31 CFU

ENTEROCOCCUS Gram positive, spherical shaped, facultative anaerobic bacteria Normally found in the digestive tracks of warm blooded animals Currently monitored in saltwater (beaches) � Samples with >104 E. coil or an average >35 per 100 ml sample indicates excessive bacteria levels

METHODS TO MONITOR FECAL BACTERIA Culturing of samples � Presence/Absence � Coliscan Eaygel � Petriflm � Colilert/Enterolert � Membrane Filtration � Multiple Tube Method

PRESENCE/ABSENCE Simplest culturing method Sample placed in a bottle containing nutrient media Color change/glow under UV or similar reaction indicates presence of the bacteria Results in 24 hours Normally used to test drinking water quality as no fecal bacteria should be present
COLISCAN EASYGEL • • • An inexpensive and easy to use test for E. coli Does not require a laboratory Tests 1 to 5 ml of sample Results in 24 to 48 hours E. coli appear dark blue to purple Results are in CFU 1 ml sample with 5 E. coli colonies

PETRIFILM Non-laboratory based test to detect E. coli bacteria Tests 1 ml of sample but can be coupled with membrane filtration to test 100 ml E. coli appear dark blue with gas bubbles Results are in CFU

COLILERT/ENTEROLERT Most popular lab based method due to relative low cost and ease of use Results in 18 to 24 hours E. coli glow under a UV light and have a yellow color Enterococcus method (for salt water) glows under a UV light but no color change Results in MPN

MEMBRANE FILTRATION Filter sample through a fine pore (~0. 6 um) filter Tests up to 100 ml of sample Results in 18 to 24 hours Colony color depends on nutrient media Results reported as CFU

MULTIPLE TUBE METHOD Not used as much due to introduction of Colilert/Enterolert Samples inoculate multiple test tubes of media/auger Results in 3 to 5 days Number of test tubes with a positive reaction determines the MPN result

SUMMARY Parameter Coliscan Easygel Petrifilm Colilert/ Enterolert No No No Yes Yes Min detection limit 0 <20 <100 <1 <1 <1 Max detection limit 1 >6000 >10, 000 Unit of measurement N/A CFU MPN Consumable cost $6. 50 $2. 50 $3. 00 $6. 50 $2. 00 $0 $1000 $15, 000 $25, 000 1 min 5 min >10 min 24 24 to 48 24 18 to 24 72 to 120 I II II III III Lab required Equipment cost Time spent per sample Incubation time (hrs) DEQ Level Status Presence/ Absence Membrane Filtration Multiple Tube

EFFECTIVE MONITORING STRATEGIES “Shotgun” method Targeted source identification/verification Carpet sampling (AKA “B-52” method) Storm event sampling

SHOTGUN METHOD • Set up sample stations scattered in the watershed • • • Sampling from public access points like bridges Ideal for initial recon to find E. coli ‘hotspot’ segments Moderate labor and cost intensive

TARGETED SAMPLING • Sample likely sources of fecal bacteria Sewer line crossings or near septic systems • Areas of known dense wildlife or animal activity • • • Good to quickly rule out or confirm fecal sources Requires planning to identify sources and may require landowner access

CARPET SAMPLING Sampling every possible source and waterbody segment Extremely labor and cost intensive Provides the most detailed picture of fecal sources

- No E. coli violations - Several E. coli violations (storm events) - Constantly high (<50%) E. coli Counts

STORM EVENT SAMPLING Sampling at the first stages of a major rainstorm � Shows the worst case scenario of site bacteria levels � Helpful in identifying sources of bacteria not readily seen during dry sample events Most effective if samples are collected within the first hour of a storm >¼” rainfall is often enough to elevate bacteria levels Storm event sampling can be a part of any plan

BEFORE HEADING OUT � Let someone know you are heading out to sample and when you expect to be back � If possible, it is good to have a co-sampler join you � Check the weather prior to going out � Dress � Inspect appropriately for expected field conditions equipment � Needed sample equipment is in good condition (coolers, sample bottles, marker, sample bucket, etc. ) � Have backup sample bottles if needed � Have safety equipment (first aid kit, flares, etc. )

IF SAMPLING ALONG A ROAD If a safe parking area away from the road is not available, pull completely off the road and onto the shoulder � Park away from sharp curves � Leave sufficient room to exit/enter the vehicle � Turn on the vehicle hazard signal � If possible, wear a reflective or orange safety vest � Try to exit away from the path of motor vehicles

BRIDGE SAFETY Be aware of traffic conditions If there is a no loitering or fishing sign, best not to sample on the bridge Sample on the upstream or the safest side of the bridge

CONTAMINATED WATER Use extra protection if water has an unusual odor or color Wear gloves or have hand sanitizer available during sampling Wash or disinfect hands after sampling and prior to eating Always assume sample water contains pathogens!

Exercise Time

Optical Brightener Monitoring to Find Intermittent Discharges Katie Register, Executive Director Clean Virginia Waterways

Monitoring for Intermittent Discharges Options: – camp out – odd hour monitoring – caulk dams – pool sampling – optical brightener monitoring

About Optical Brighteners • Laundry detergents are highly fluorescent due to optical brighteners that are added • Makes white “whiter” • OB do not occur in nature

• Gain insight into the history of an outfall without being physically present • Simple presence or absence test

The OBM Process Fabric swatch is key – Must never have been exposed to detergents – Purchasing information at end of this presentation

The OBM Process Various traps & anchoring techniques. Can be made with PVC, hose clamps, brick & wire.

The OBM Process If you use cotton pads (as opposed to fabric), you can make a trap using wire mesh.

The OBM Process Place in streams or in outfall for several days. 7 days is good. Best in low flow situations. – Prevent contamination, wear gloves. – Secure it with monofilament for retrieval.

The OBM Process Retrieve samples. Rinse off sediment. Label the fabric swatches (dates, location) Dry the fabric swatches (not in direct sunlight)

The OBM Process • Place under a long-wavelength UV light. Compare to non-exposed fabric • Fluorescence = positive signature for household waste water in the stream. • Specks or spots of fluorescence on fabric can be ignored.

Fabric treated with various levels of Tide laundry soap. From: Illicit Discharge Detection and Elimination: A Guidance Manual for Program Development and Technical Assessments http: //cfpub 1. epa. gov/npdes/stormwater/idde. cfm

When to use OBM To isolate intermittent discharges – Dry weather flows – When you suspect faulty septic systems – Storm drain cross-connections – Want animal/human waste differentiation

OBM • Not suitable for enforcement action but when done in combination with a larger sampling program is a valuable indicator in helping to identify problem • Bacteria, field observations, etc.

Photo: EPA, 2009

Photo: EPA, 2009

Photo: EPA, 2009

Pros of using OBM • Simple, cost effective • Sensitive to intermittent discharges of undiluted laundry water • Minimal safety & waste disposal concerns • Suitable for volunteer monitors

Costs • • • 100 cotton pads (Free of OB) for $13 Wire cages or PVC pipe + hose clamp Monofilament line Rubber gloves long-wavelength UV light $250 to $350

Case Studies • Massachusetts – routine OBM tested positive, yet low bacterial counts. Testing upstream found direct discharge of washing machine (done to reduce flow to a stressed septic system)

Case Studies • Massachusetts – High bacterial counts in a sewered city indicated animals as source. • So they did OBM which came back positive. Answer was leaking sanitary sewer pipe. • OBM also helped find an older section of town that was never tied into the central sewer system

Case Studies • Licensed septic pumper washing down his equipment into a storm drain that discharges to a shellfish area. His license was revoked by the Board of Health.

Learn more… • An Optical Brightener Handbook by Dave Sargent & Waye Castonguay. 1998. • EPA ‘s National Pollutant Discharge Detection & Elimination & Stormwater web sites • A lesson plan by Clean VA Waterways: • www. longwood. edu/cleanva/teachersvawatercurriculum. htm

Cotton fabric & pads

Cotton fabric • Cotton fabric suitable for PVC pipe: Ozark Underground Lab sells fabric for $1. 25 per piece. 417 -785 -4289 or jstearman@ozarkundergroundlab. com • VWR International sells cotton pads suitable for use in wire trap. 100 for $13. Item 21902985. 1 -800 -932 -5000

Thank you www. longwood. edu/Clean. Va cleanva@longwood. edu

Photo: EPA, 2009
- Slides: 51